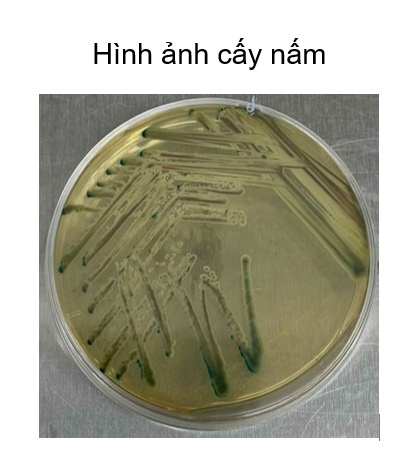

Candida albican là nấm men thường trú ở niêm mạc miệng-hầu họng, ở trạng thái cân bằng bình thường, nấm không gây hại. Tần suất nhiễm nấm đang tăng lên nhanh chóng trong vòng 20 năm qua do sự gia tăng của quần thể có nguy cơ nhiễm nấm. Viêm phổi do nấm ngày càng gia tăng, yếu tố thuận lợi chủ yếu liên quan đến việc sử dụng thuốc ức chế miễn dịch, lạm dụng kháng sinh,…Các tác nhân gây bệnh nấm phổi thường gặp Candida spp., Aspergillus spp., Cryptococus spp.,…Mặc dù
Candida chiếm hơn 2/3 các trường hợp phân lập được, chẩn đoán viêm phổi do Candida rất khó khăn do biểu hiện lâm sàng không điển hình, hình ảnh học không đặc trưng gợi ý, các dấu ấn sinh học không đặc hiệu và thường cần mô bệnh học để chẩn đoán đặc hiệu.
Một trường hợp lâm sàng tại khoa Nội tổng hợp, bệnh nhân nam L.V.R 80 tuổi, vào viện vì sốt, tiêu lỏng kèm khó thở, nặng ngực. Tiền sử tăng huyết áp, chưa ghi nhân bệnh lý hô hấp, bệnh mạn tính khác trước đó. Bệnh nhân nhập viện với tình trạng nhiễm trùng nhiễm độc, tổn thương thận cấp. Trong quá trình nằm viện bệnh nhân khó thở tăng dần suy hô hấp, sốt cao dao động 39 – 400C, đáp ứng kém với phác đồ kháng sinh ban đầu (piperacillin/tazobactam + levofloxacin). Bệnh nhân được nội soi phế quản, sau 5 ngày nhập viện kết quả cấy dịch rửa phế quản Candida albican, bệnh nhân được chỉ định phối hợp sử dụng kháng nấm anidulafungin. Sau 4 ngày sử dụng kháng nấm, lâm sàng bệnh nhân cải thiện hết sốt, ngưng được oxy, thở đều êm, chức năng thận hồi phục.
Bệnh nhân được tiếp tục duy trì phác đồ kháng nấm anidulafugin và fluconazole (hạ bậc kháng nấm), trong quá trình điều trị bệnh nhân được khám chuyên khoa mắt, theo dõi men gan, chức năng thận, bilan nhiễm trùng cũng như hình ảnh học (CTscan ngực, xquang ngực thẳng). Dưới đây một vài hình ảnh học trong quá trình điều trị nội, ngoại trú.

.jpg)

Việc chẩn đoán xác định nhiễm nấm Candida xâm lấn khi cấy nấm dương tính trong máu, dịch màng phổi, dịch não tủy hoặc mô bệnh học. Chẩn đoán « nhiều khả năng nhiễm Candida xâm lấn » được cân nhắc khi thỏa mãn các tiêu chí sau :
- Yếu tố nguy cơ
- Lâm sàng : giảm bạch cầu hạt hoặc sốt kéo dài hoặc sốc nhiễm trùng không rõ nguyên nhân sau 4-7 ngày sử dụng kháng sinh phổ rộng.
- Cận lâm sàng : kháng nguyên Mannan hoặc kháng thể antimanan dương tính hoặc PCR dương tính hoặc cấy Candida dương tính từ dịch rửa phể quản phế nang hoặc đàm.
Quyết định khởi trị kháng nấm sớm cần được cá thể hóa dựa trên nguy cơ và cá thể hóa bệnh nhân. Điều trị nhiễm nấm xâm lấn bằng kháng nấm tĩnh mạch gặp nhiều thách thức lâm sàng: thường đòi hỏi chi phí điều trị khá cao bao gồm thuốc đặc hiệu, thời gian nằm viện dài ngày. Ngoài ra, đòi hỏi theo dõi chặt chẽ chức năng gan, chức năng thận, điện giải, theo dõi tương tác thuốc và điều chỉnh liều giúp giảm thiểu nguy cơ độc tính, góp phần nâng cao an toàn và tiên lượng bệnh nhân.
Ths.Bs. Mai Thị Thùy Linh, ThS.Bs. Dương Thị Thanh Vân
KHOA NỘI TỔNG HỢP